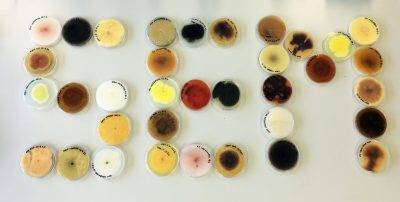
10-Acendrado

Acendrado
Publicada el 22/01/2026
Título: Acendrado
Autor: Alexandra La Mura Arroyo
Facultad de Ciencias Biológicas, Universidad de Valencia, C/ Dr. Moliner, 50. 46100 Burjassot - Valencia.
Descripción: Conjunto de placas de diferentes especies de hongos aisladas a partir del extracto de raíces de distintas plantas, como maíz, trigo o girasol, entre otras. El medio de cultivo utilizado para el aislamiento es PDA (Potato Dextrose Agar).